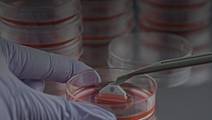
ReachMD Healthcare Image
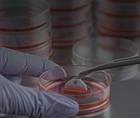
ReachMD Healthcare Image

526-540 of 607
Understanding the Causes of Major Birth Defects: Steps to Prevention
Grand Rounds Nation®Understanding the Causes of Major Birth Defects: Steps to Prevention
The Poisoner’s Handbook: Murder and the Birth of Forensic Medicine in Jazz Age New York
Book ClubThe Poisoner’s Handbook: Murder and the Birth of Forensic Medicine in Jazz Age New York
Global Efforts to Eradicate River Blindness
World Medical NewsGlobal Efforts to Eradicate River Blindness
Gates Foundation Predicts Global Health Breakthroughs by 2030
World Medical NewsGates Foundation Predicts Global Health Breakthroughs by 2030
- advertisement
Stem Cell Therapy for Neuropathic Trigeminal Pain
World Medical NewsStem Cell Therapy for Neuropathic Trigeminal Pain
First Newborn Organ Transplant Performed in the UK
World Medical NewsFirst Newborn Organ Transplant Performed in the UK
Unusual Transplant-associated Infections: Just How Unusual?
Grand Rounds Nation®Unusual Transplant-associated Infections: Just How Unusual?
- advertisement
Pre-Exposure Prophylaxis for Prevention of HIV
Grand Rounds Nation®Pre-Exposure Prophylaxis for Prevention of HIV
Time for Public Health Action on Infertility
Grand Rounds Nation®Time for Public Health Action on Infertility
Antenatal/ Adolescent Depression Link
What Your Patients Are Talking AboutAntenatal/ Adolescent Depression Link